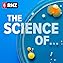

Sweat
Échec de l'ajout au panier.
Échec de l'ajout à la liste d'envies.
Échec de la suppression de la liste d’envies.
Échec du suivi du balado
Ne plus suivre le balado a échoué
-
Narrateur(s):
-
Auteur(s):
À propos de cet audio
Simon Morton and Alison Ballance present a three-part series exploring the science of sweat, virtual reality and Vitamin C. This week, the function of a much-maligned bodily fluid that plays a vital role in keeping us humans healthy and alive.
Human sweat - 99 percent water with a dash of salts and a pH of around 4.5, is a much-maligned bodily fluid that plays a vital role in keeping us humans healthy and alive.
The word's become shorthand for hard work and discomfort but without it human life just wouldn't be the same: if our prehistoric ancestors hadn't been able to sweat they could never have stayed cool for long enough to chase down their prey on the ancient Savannah.
What happens when we sweat?
People sweat for all sorts of reasons; emotional sweating when we're stressed, scared or in pain, or the sweat we get on our forehead when we eat spicy foods. There's the night sweats that people suffer during menopause, and the sweating people experience when they are withdrawing from drugs.
But the most common encounter we have with sweat is for thermo-regulation, for cooling us down when we get too hot running for the bus, in humid weather, or when we exercise. When we heat up, the hypothalamus in our brain detects that our body and skin temperature is rising and using a neurotransmitter called acetylcholine it sends a signal to stimulate millions of eccrine sweat glands to release a salty liquid- sweat- via ducts onto our skin to evaporate and cool the body down.
These eccrine glands are spread out over most of your body but you have higher concentrations on the palms of your hands, the soles of your feet, your underarms and your forehead. The sweat from these eccrine glands is mostly water and salt and doesn't tend to smell.
There's another type of sweat gland called the apocrine gland that can be more problematic. These glands are concentrated in the underarm and groin and from puberty onwards secrete a more oily sweat full of proteins and lipids when you get hot or stressed out and anxious. Although apocrine sweat is sterile when it hits the skin's surface, the bacteria living on you love to eat this gooey goodness, and then excrete the volatile compounds that we sniff as body odour.
The role of our microbes in making us smell
"Hot and humid, the armpit populated by bacteria cursed with creating a noxious odor. That smell, however, has proved lucrative. Today more than 90 percent of Americans use some sort of armpit cosmetic, creating a worldwide deodorant bonanza worth $18 billion." Terrence McCoy in The Washington Post…
Go to this episode on rnz.co.nz for more details